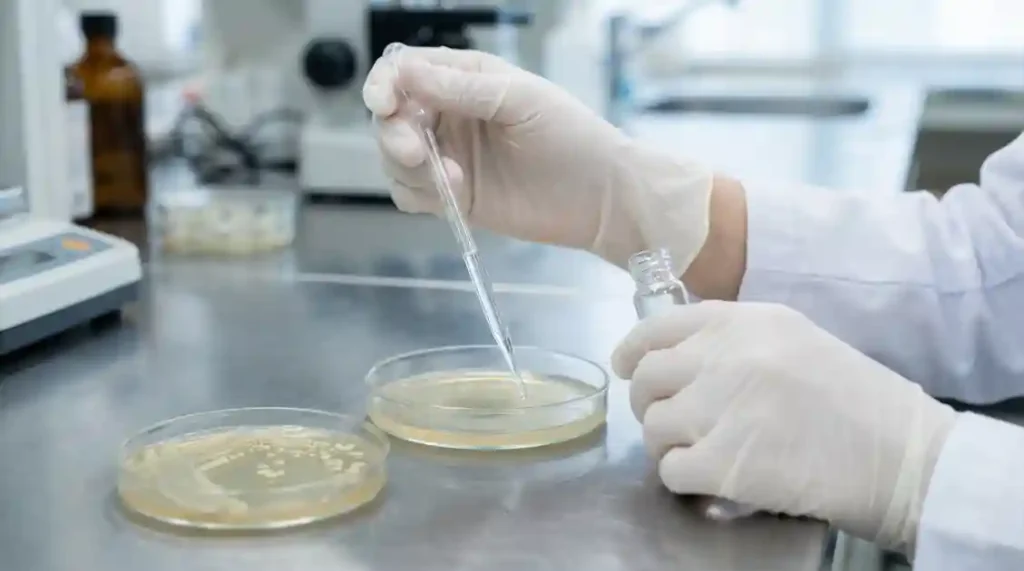

衛生検査技師は、公衆衛生の維持向上に貢献する医療専門職です。
病気の診断や治療を目的とする臨床検査技師とは異なり、主に環境衛生や食品衛生、感染症対策など、社会全体の健康を守るための検査を行います。
しかし、その制度は複雑であり、臨床検査技師との違いや現在の立ち位置について疑問を持つ人も少なくありません。
本記事では、衛生検査技師の具体的な仕事内容、臨床検査技師との法的な違い、現在の資格の現状、そして公衆衛生分野で専門性が活きる領域までを詳しく解説します。
公衆衛生の最前線で活躍する衛生検査技師のリアルな姿に迫りましょう。
衛生検査技師が担う役割と資格の現状

衛生検査技師は、かつては臨床検査技師とは別の独立した資格として存在しました。
しかし、法改正によりその位置づけは大きく変化しています。
ここでは、衛生検査技師が公衆衛生分野で果たす役割と、現在の資格制度の現状について解説します。
公衆衛生の維持向上への貢献
衛生検査技師の主な役割は、感染症の発生予防や拡大防止、食品の安全確保、環境汚染の監視など、公衆衛生の維持向上に貢献することです。
具体的には、病原菌の検査、食品中の有害物質の分析、水質・大気汚染の測定などを行い、その結果を行政機関や医療機関に報告します。
これにより、地域住民の健康と安全が守られます。
臨床検査技師との法的な違いと統合の経緯
かつては「衛生検査技師法」に基づき、衛生検査技師と臨床検査技師は別々の資格でした。
しかし、業務内容の重複や医療現場のニーズの変化に伴い、2005年に「臨床検査技師等に関する法律」に統合されました。
これにより、衛生検査技師の新規養成は停止され、現在は臨床検査技師が衛生検査技師の業務も行えるようになっています。
ただし、統合前に衛生検査技師の資格を取得した人は、引き続きその資格で業務に従事できます。
希少な資格としての側面
新規養成が停止されたため、衛生検査技師の資格を持つ人は年々減少しています。
そのため、現在この資格を持つ人は希少な存在です。
特に、公衆衛生分野での専門知識と経験は、感染症のパンデミック時など、社会的に大きな価値を持つことがあります。
衛生検査技師の具体的な業務と活躍の場
衛生検査技師の業務は、主に検体検査が中心となりますが、その活躍の場は多岐にわたります。
ここでは、具体的な業務内容と、病院以外の主要な活躍の場について詳しく見ていきましょう。
検体検査の専門性
衛生検査技師は、病原微生物の分離・同定、食品中の細菌検査、水質検査、公衆浴場やプールの水質検査など、多岐にわたる検体検査を行います。
これらの検査は、感染症の流行を未然に防いだり、食中毒の原因を特定したりするために不可欠です。
高度な微生物学や化学の知識、そして正確な分析技術が求められます。
病院以外の主要な活躍の場
衛生検査技師の主な活躍の場は、病院の検査室よりも、臨床検査センター、保健所、環境衛生研究所、食品衛生研究所、製薬会社、食品メーカーなどです。
特に、臨床検査センターでは、病院から委託された検体検査を大量に処理し、公衆衛生に関わる検査も多く担当します。
保健所や研究所では、地域住民の健康を守るための調査研究や検査指導を行います。
行政機関での実務
保健所や地方自治体の環境衛生部門では、衛生検査技師の専門知識が行政サービスに直結します。
例えば、感染症発生時の疫学調査や、食品関連施設への立ち入り検査、水質汚染の原因究明など、公衆衛生行政の最前線で活躍できます。
法令に基づいた検査や指導を行うため、法的な知識も必要です。
衛生検査技師のやりがいと直面する制度上の課題

衛生検査技師は、社会の健康と安全を守るという大きな使命感を持って働けるやりがいのある仕事です。
しかし、その一方で、資格制度の特殊性からくる課題も存在します。
ここでは、現場で働く技師が日々感じている喜びと、直面する現実について解説します。
社会貢献の実感と達成感
自身の検査結果が、感染症の拡大防止や食中毒の予防、環境汚染の改善に直接つながることは、衛生検査技師にとって大きなやりがいです。
目に見えない脅威から人々を守るという社会貢献の実感は、この仕事ならではの達成感となります。
特に、大規模な感染症発生時などには、その専門性が高く評価されます。
検査のプロとしての誇り
微生物学、化学、公衆衛生学など、幅広い専門知識と高度な検査技術を駆使して、正確なデータを提供する検査のプロとしての誇りを持てます。
複雑な分析や原因究明に成功した際には、自身の専門性が社会に役立っていることを強く実感できるでしょう。
業務範囲の制限とキャリアパスの検討
衛生検査技師は、臨床検査技師と異なり、採血や心電図などの生理学的検査を行うことができません。
この業務範囲の制限は、キャリアパスを考える上で課題となる場合があります。
そのため、臨床検査技師の資格も併せ持つことで、より幅広い業務に対応でき、キャリアの選択肢を広げられます。
衛生検査技師に必要な専門知識とキャリアの積み方

衛生検査技師として働くためには、特定の専門知識と、現在の資格制度を理解した上でのキャリアプランニングが重要です。
ここでは、資格取得の背景と、活躍するために必要な能力について解説します。
資格取得の背景と現在のルート
衛生検査技師の資格は、2005年の法改正以前に、大学や短期大学で指定された科目を履修し、卒業することで取得できました。
現在は新規養成が停止されているため、新たに衛生検査技師の資格だけを取得することはできません。
しかし、臨床検査技師の資格を取得すれば、衛生検査技師の業務範囲もカバーできます。
そのため、これから検査技師を目指す場合は、臨床検査技師の養成課程に進むのが一般的です。
微生物学・化学・公衆衛生学の深い知識
衛生検査技師には、病原微生物の特性、化学物質の分析方法、公衆衛生に関する法令や疫学など、幅広い専門知識が求められます。
これらの知識を基に、検査結果を正確に解釈し、適切な対策を提案する能力が重要です。
精度管理と分析能力
検査結果の信頼性を確保するためには、機器の精度管理や、分析手法の妥当性を評価する能力が不可欠です。
常に最新の技術動向を把握し、より正確で効率的な検査方法を追求する姿勢が求められます。
衛生検査技師の専門性が活きる領域

衛生検査技師の資格制度は変化しましたが、公衆衛生分野における検査の重要性は増すばかりです。
特に、グローバル化や環境問題の深刻化に伴い、衛生検査技師の専門性が活きる領域は拡大しています。
例えば、新たな感染症の発生や海外からの侵入リスクが高まる中で、病原体の迅速な特定と分析は、パンデミックを防ぐ上で極めて重要です。
また、食品の安全性や環境汚染問題への対応、水質や土壌、大気中の有害物質のモニタリングといった分野では、高度な分析機器を操作する技術と、検査結果を正確に評価する専門知識が求められます。
衛生検査技師は、これらの社会課題に対し、科学的な根拠に基づいた解決策を提供する重要な役割を担います。
資格制度は変化しても、その専門性は現代社会において不可欠な存在であり続けるでしょう。









